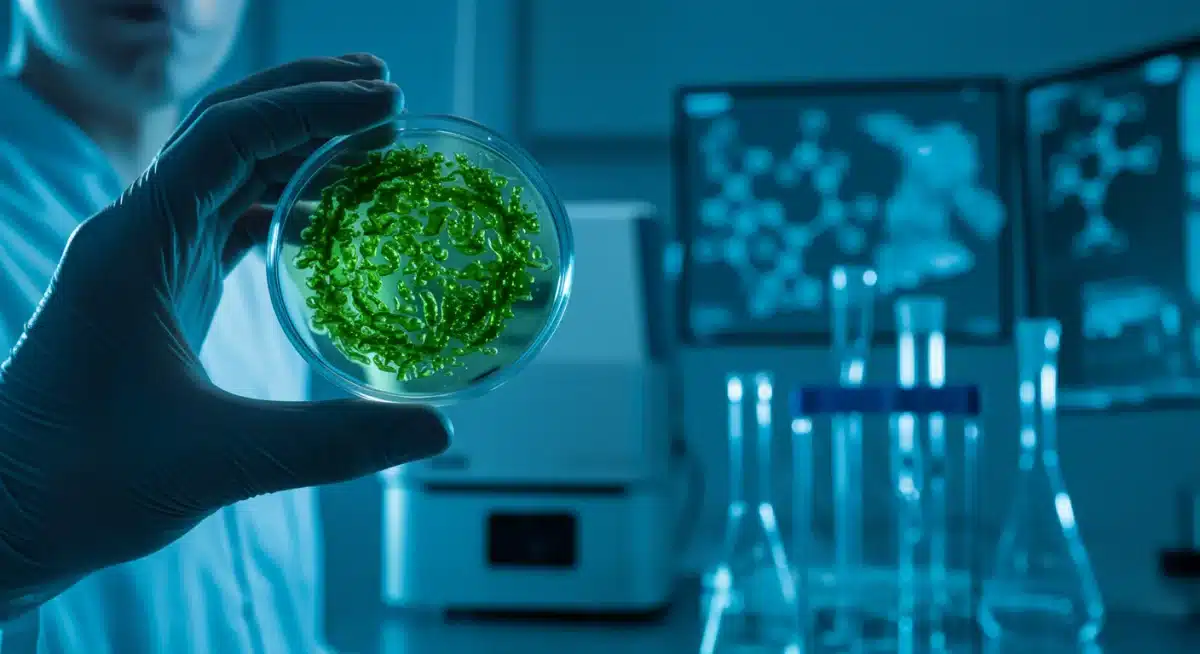
Cientista examinando cultura de microalgas para produção de biocombustíveis em laboratório avançado.

Tecnologias Sustentáveis 2025: Inovações Brasileiras Contra Mudanças Climáticas

Anúncios
As tecnologias sustentáveis brasileiras 2025 representam um avanço crucial na luta contra as mudanças climáticas, destacando-se por soluções inovadoras que prometem transformar diversos setores, desde a produção de energia até a gestão de resíduos, posicionando o Brasil como um polo de desenvolvimento verde.
Anúncios
O Brasil, um país com uma biodiversidade ímpar e um potencial gigantesco para a inovação, está na vanguarda do desenvolvimento de tecnologias sustentáveis brasileiras 2025 que prometem revolucionar a forma como enfrentamos as mudanças climáticas. Essas inovações não apenas buscam mitigar os impactos ambientais, mas também pavimentam o caminho para um futuro mais próspero e equilibrado. Prepare-se para conhecer as soluções que estão moldando um amanhã mais verde.
Anúncios
A Ascensão das Energias Renováveis e Armazenamento no Brasil
A transição energética é um dos pilares fundamentais no combate às mudanças climáticas, e o Brasil tem se destacado globalmente na produção de energia limpa. Em 2025, a expectativa é que as inovações no setor de energias renováveis e sistemas de armazenamento atinjam um novo patamar, consolidando a posição do país como líder em sustentabilidade energética.
A abundância de recursos naturais, como sol e vento, confere ao Brasil uma vantagem competitiva significativa. No entanto, a eficiência e a capacidade de armazenamento dessas energias intermitentes são cruciais para a sua plena integração à matriz energética nacional. Projetos inovadores estão focando exatamente nesses desafios, buscando soluções que garantam a estabilidade e a acessibilidade da energia renovável para todos os brasileiros.
Inovação em Painéis Solares e Microgeração Distribuída
A tecnologia fotovoltaica tem avançado rapidamente no Brasil, com a popularização dos sistemas de microgeração distribuída. Em 2025, espera-se que novos painéis solares, mais eficientes e duráveis, estejam disponíveis, além de modelos com designs integrados à arquitetura, tornando-os mais estéticos e funcionais. Esses avanços facilitam a adoção da energia solar em residências e empresas, reduzindo a dependência de fontes fósseis e diminuindo a pegada de carbono.
- Painéis Perovskitas: Prometem maior eficiência e menor custo de produção, com flexibilidade para aplicações diversas.
- Tecnologias Bifaciais: Capazes de captar luz solar de ambos os lados, aumentando a geração de energia.
- Sistemas de Monitoramento Inteligente: Otimizam a performance e identificam falhas em tempo real.
Armazenamento de Energia: Baterias e Além
O armazenamento de energia é vital para superar a intermitência das fontes renováveis. Embora as baterias de íon-lítio dominem o mercado, o Brasil está investindo em pesquisas para alternativas mais sustentáveis e de baixo custo. Em 2025, poderemos ver o surgimento de baterias de fluxo ou de estado sólido, que oferecem maior segurança e ciclos de vida mais longos, além de sistemas de armazenamento térmico e hidrogênio verde, que prometem transformar a maneira como a energia é guardada e utilizada.
A integração dessas tecnologias de armazenamento com redes inteligentes (smart grids) é fundamental para garantir a estabilidade do fornecimento de energia, mesmo em períodos de baixa irradiação solar ou ventos fracos. Essa sinergia entre geração, armazenamento e distribuição é a chave para um futuro energético verdadeiramente sustentável no Brasil.
Em suma, as inovações em energias renováveis e armazenamento no Brasil são cruciais para a descarbonização da matriz energética. A contínua pesquisa e desenvolvimento nesse setor não apenas impulsionam a sustentabilidade, mas também geram empregos e promovem o desenvolvimento econômico do país.
Biocombustíveis Avançados: A Revolução Verde na Mobilidade e Indústria
O setor de transportes e a indústria pesada são grandes emissores de gases de efeito estufa. No Brasil, o desenvolvimento de biocombustíveis avançados representa uma alternativa promissora para descarbonizar essas áreas. Em 2025, espera-se que as tecnologias de produção de biocombustíveis de segunda e terceira geração estejam mais consolidadas, oferecendo soluções mais eficientes e com menor impacto ambiental do que os biocombustíveis tradicionais.
A pesquisa brasileira tem se concentrado na utilização de matérias-primas não alimentares e resíduos agrícolas, evitando a competição com a produção de alimentos e maximizando o aproveitamento de recursos. Essa abordagem inovadora posiciona o Brasil como um player estratégico no cenário global de energia renovável.
Etanol de Segunda Geração (E2G) e Biogás/Biometano
O etanol de segunda geração, produzido a partir da biomassa lignocelulósica (como bagaço e palha de cana-de-açúcar), é uma das apostas do Brasil para 2025. Essa tecnologia permite a produção de combustível com um balanço energético muito mais favorável e menor pegada de carbono. Além disso, o biogás e o biometano, gerados a partir da decomposição de resíduos orgânicos, estão ganhando destaque como substitutos do gás natural, tanto para veículos quanto para a geração de energia elétrica.
- Processos Enzimáticos: Novas enzimas que otimizam a quebra da celulose para produção de E2G.
- Digestores Anaeróbios Otimizados: Aumento da eficiência na produção de biogás a partir de resíduos agrícolas e urbanos.
- Uso Integrado: Combinação de produção de biocombustíveis com sistemas de tratamento de efluentes.
Biocombustíveis de Terceira Geração: Algas e Outros Micro-organismos
A pesquisa com biocombustíveis de terceira geração, especialmente aqueles derivados de microalgas, é uma área de grande potencial no Brasil. As microalgas são capazes de crescer rapidamente, absorver grandes quantidades de CO2 e produzir óleos que podem ser convertidos em biodiesel ou biojetfuel. Embora ainda em fase de desenvolvimento, a expectativa é que, em 2025, projetos-piloto em escala comercial comecem a despontar, abrindo caminho para uma nova era de combustíveis sustentáveis.
Essas inovações não se limitam apenas ao combustível. Os subprodutos da biomassa e das microalgas podem ser utilizados na produção de biofertilizantes, ração animal e outros produtos de alto valor agregado, criando uma economia circular e maximizando os benefícios ambientais e econômicos. O Brasil, com sua vasta extensão territorial e clima favorável, tem todas as condições para liderar essa revolução verde.
Em retrospecto, os biocombustíveis avançados representam uma das mais promissoras tecnologias sustentáveis brasileiras 2025. A contínua pesquisa e o investimento em infraestrutura são fundamentais para que o país capitalize seu potencial e ofereça soluções de descarbonização para o mundo.
Agricultura Sustentável e Biotecnologia: Produzindo Mais com Menos Impacto
A agricultura é um setor vital para a economia brasileira, mas também um dos que mais contribuem para as emissões de gases de efeito estufa e o desmatamento. As tecnologias sustentáveis brasileiras 2025 na área agrícola e da biotecnologia estão focadas em aumentar a produtividade e a resiliência das culturas, ao mesmo tempo em que reduzem o uso de insumos químicos e o impacto ambiental. A meta é garantir a segurança alimentar global sem comprometer os recursos naturais.
A combinação de técnicas de agricultura de precisão, biotecnologia e manejo sustentável do solo está transformando a paisagem agrícola brasileira, tornando-a mais eficiente e ecologicamente responsável. Essas inovações são essenciais para a adaptação às mudanças climáticas e a construção de um futuro alimentar mais seguro.
Agricultura de Precisão e Digitalização no Campo
A agricultura de precisão, que utiliza dados e tecnologias como GPS, sensores e drones, tem se expandido rapidamente no Brasil. Em 2025, a expectativa é que a digitalização do campo seja ainda mais avançada, com o uso de inteligência artificial para otimizar o uso de água, fertilizantes e defensivos agrícolas. Isso não só reduz custos para os produtores, mas também minimiza a contaminação do solo e da água, promovendo uma produção mais sustentável.
- Sensores de Solo e Clima: Monitoramento em tempo real para aplicação precisa de recursos.
- Drones para Pulverização e Mapeamento: Redução do desperdício e otimização da cobertura.
- Plataformas de Análise de Dados: Auxiliam na tomada de decisões estratégicas para o cultivo.
Biotecnologia e Bioinsumos
A biotecnologia oferece soluções inovadoras para a agricultura, como o desenvolvimento de culturas mais resistentes a pragas e doenças, o que diminui a necessidade de pesticidas. Além disso, os bioinsumos – como biofertilizantes e biopesticidas – estão ganhando espaço, substituindo produtos químicos sintéticos por alternativas naturais e menos agressivas ao meio ambiente. Em 2025, espera-se que a biotecnologia brasileira continue a desenvolver novas variedades de plantas adaptadas às condições climáticas extremas e a otimizar a produção de bioinsumos em larga escala.
Essas abordagens biotecnológicas não apenas protegem o meio ambiente, mas também contribuem para a saúde humana, ao reduzir a exposição a produtos químicos. A pesquisa brasileira nesse campo é fundamental para garantir a sustentabilidade da produção agrícola e a segurança alimentar para as futuras gerações.
Em conclusão, a agricultura sustentável e a biotecnologia são pilares para a resiliência do Brasil diante das mudanças climáticas. As tecnologias sustentáveis brasileiras 2025 nesse setor visam uma produção mais eficiente, limpa e adaptada aos desafios ambientais.
Gestão de Resíduos e Economia Circular: Transformando Lixo em Recurso
A gestão inadequada de resíduos é um problema global que contribui significativamente para a poluição do solo, da água e do ar, além de gerar emissões de metano, um potente gás de efeito estufa. No Brasil, o conceito de economia circular, aliado a novas tecnologias sustentáveis brasileiras 2025 para o tratamento de resíduos, está ganhando força. A ideia é transformar o que antes era considerado lixo em novos recursos, minimizando o desperdício e fechando os ciclos de produção.
Essas inovações não apenas mitigam os impactos ambientais, mas também criam novas oportunidades de negócios, geram empregos e promovem um uso mais eficiente dos recursos naturais. O Brasil, com seu vasto potencial de geração de resíduos, tem um campo fértil para o desenvolvimento e aplicação dessas tecnologias.
Reciclagem Avançada e Upcycling
A reciclagem tradicional é importante, mas as inovações em 2025 vão além. A reciclagem avançada, que utiliza processos químicos e físicos para transformar materiais complexos em matérias-primas de alta qualidade, está se desenvolvendo no Brasil. O upcycling, por sua vez, foca na criação de produtos de maior valor a partir de resíduos, como a transformação de plásticos em materiais de construção ou tecidos em novos produtos de moda. Essas tecnologias reduzem a necessidade de extração de novas matérias-primas e diminuem a quantidade de lixo em aterros.
- Pirólise e Gaseificação: Processos que convertem resíduos plásticos em combustíveis ou produtos químicos.
- Tecnologias de Separação Inteligente: Utilizam IA e robótica para otimizar a triagem de materiais recicláveis.
- Materiais Compósitos de Resíduos: Criação de novos materiais a partir da combinação de diferentes tipos de lixo.
Compostagem e Biodigestão de Resíduos Orgânicos
Os resíduos orgânicos representam uma parcela significativa do lixo brasileiro. Em 2025, espera-se que as tecnologias de compostagem e biodigestão estejam mais difundidas, transformando esses resíduos em adubo orgânico de alta qualidade (compostagem) ou biogás/biometano (biodigestão). A biodigestão, em particular, é uma solução de dupla face: gera energia limpa e reduz as emissões de metano dos aterros sanitários, contribuindo diretamente para o combate às mudanças climáticas.
A implementação em larga escala dessas tecnologias requer investimento em infraestrutura e educação da população. No entanto, os benefícios ambientais e econômicos são inegáveis, tornando a gestão de resíduos uma área chave para a sustentabilidade brasileira. A transição para uma economia circular é um caminho sem volta, e o Brasil está se posicionando para ser um líder nesse movimento.
Em suma, a gestão de resíduos e a economia circular são essenciais para transformar o cenário ambiental brasileiro. As tecnologias sustentáveis brasileiras 2025 nesse campo oferecem soluções inovadoras para um futuro com menos lixo e mais recursos.
Cidades Inteligentes e Infraestrutura Verde: Construindo o Futuro Urbano
As cidades são os maiores centros de consumo de energia e produção de resíduos, sendo, portanto, pontos críticos na luta contra as mudanças climáticas. No Brasil, o conceito de cidades inteligentes e infraestrutura verde está evoluindo rapidamente, com o desenvolvimento de tecnologias sustentáveis brasileiras 2025 que visam tornar os centros urbanos mais eficientes, resilientes e habitáveis. A integração de tecnologia e natureza é a chave para criar ambientes urbanos que promovam o bem-estar dos cidadãos e minimizem o impacto ambiental.
Essas inovações não se limitam apenas à eficiência energética ou à gestão de resíduos; elas abrangem desde a mobilidade urbana até a criação de espaços verdes e a utilização inteligente da água, construindo cidades que são verdadeiros ecossistemas urbanos.
Mobilidade Urbana Sustentável
A mobilidade urbana é um dos maiores desafios das cidades brasileiras. Em 2025, espera-se que a infraestrutura para veículos elétricos e híbridos esteja mais desenvolvida, com estações de recarga mais acessíveis e eficientes. Além disso, o transporte público inteligente, com sistemas de otimização de rotas e monitoramento em tempo real, contribuirá para a redução do congestionamento e das emissões. A micromobilidade, com bicicletas e patinetes elétricos, também ganhará mais espaço, especialmente em cidades com infraestrutura cicloviária adequada.
- Ônibus e Trens Elétricos: Expansão das frotas e linhas de transporte público movido a energia limpa.
- Sistemas de Compartilhamento: Aumento da disponibilidade de veículos e bicicletas elétricas compartilhadas.
- Infraestrutura Cicloviária Inteligente: Ciclovias com iluminação e sinalização responsivas.
Edificações Sustentáveis e Urbanismo Verde
A construção civil é um setor com grande potencial para a sustentabilidade. Em 2025, as edificações sustentáveis, com certificações como LEED e AQUA, serão mais comuns, incorporando tecnologias como telhados verdes, sistemas de captação de água da chuva e materiais de construção de baixo impacto ambiental. O urbanismo verde, por sua vez, foca na criação de parques, jardins verticais e corredores ecológicos que melhoram a qualidade do ar, reduzem as ilhas de calor e promovem a biodiversidade nas cidades.
A integração dessas soluções de infraestrutura verde com tecnologias inteligentes, como sistemas de irrigação automatizados e iluminação pública eficiente, cria cidades mais resilientes e agradáveis para se viver. O planejamento urbano sustentável é fundamental para mitigar os efeitos das mudanças climáticas e garantir um futuro saudável para as gerações futuras.
Em suma, as cidades inteligentes e a infraestrutura verde são cruciais para o desenvolvimento urbano sustentável. As tecnologias sustentáveis brasileiras 2025 nesse campo visam criar ambientes urbanos mais eficientes, resilientes e ecologicamente equilibrados.
Monitoramento Ambiental e Soluções Baseadas na Natureza: Protegendo Nossos Ecossistemas
A conservação dos ecossistemas naturais é uma das estratégias mais eficazes no combate às mudanças climáticas, pois florestas e oceanos atuam como grandes sumidouros de carbono. No Brasil, o desenvolvimento de tecnologias sustentáveis brasileiras 2025 para o monitoramento ambiental e a implementação de soluções baseadas na natureza são essenciais para proteger a rica biodiversidade do país e garantir a resiliência dos ecossistemas.
Essas inovações utilizam ferramentas de ponta para coletar dados, prever impactos e implementar ações de restauração, demonstrando que a tecnologia pode ser uma aliada poderosa na conservação ambiental.
Monitoramento por Satélite e Inteligência Artificial
O desmatamento na Amazônia e em outros biomas brasileiros é uma preocupação constante. Em 2025, as tecnologias de monitoramento por satélite, combinadas com algoritmos de inteligência artificial, serão ainda mais precisas e rápidas na detecção de desmatamento ilegal, incêndios e outras ameaças ambientais. Esses sistemas permitem uma resposta mais ágil das autoridades e a implementação de políticas de conservação mais eficazes. Além disso, o uso de IA para analisar grandes volumes de dados ambientais ajuda a identificar padrões e prever riscos, otimizando a tomada de decisões.
- Sensores Remotos de Alta Resolução: Detecção de pequenas alterações na cobertura vegetal.
- Algoritmos de Aprendizado de Máquina: Identificação automática de focos de desmatamento e queimadas.
- Plataformas de Visualização de Dados: Acesso público e transparente a informações ambientais.
Restauração Ecológica e Soluções Baseadas na Natureza (SbN)
A restauração de áreas degradadas é crucial para recuperar a biodiversidade e aumentar a capacidade de sumidouro de carbono dos ecossistemas. Em 2025, o Brasil estará investindo em tecnologias para otimizar os processos de restauração ecológica, como o uso de drones para semeadura de sementes e o desenvolvimento de técnicas de bioengenharia para a recuperação de solos. As Soluções Baseadas na Natureza (SbN), que utilizam os próprios ecossistemas para resolver desafios ambientais, como a criação de zonas úmidas para tratamento de efluentes ou a recuperação de mangues para proteção costeira, ganharão destaque.
Essas abordagens não apenas restauram a saúde dos ecossistemas, mas também oferecem benefícios sociais e econômicos para as comunidades locais, como a geração de renda através do ecoturismo e da produção sustentável. O Brasil, com seus vastos biomas, tem um papel fundamental a desempenhar na implementação e disseminação dessas soluções.
Em resumo, o monitoramento ambiental e as soluções baseadas na natureza são vitais para a proteção dos ecossistemas brasileiros. As tecnologias sustentáveis brasileiras 2025 nesse campo promovem a conservação da biodiversidade e a resiliência climática do país.
Desafios e Oportunidades para as Tecnologias Sustentáveis Brasileiras em 2025
Enquanto o Brasil avança no desenvolvimento de tecnologias sustentáveis brasileiras 2025, é crucial reconhecer os desafios inerentes a essa jornada e as vastas oportunidades que se abrem. A inovação não ocorre no vácuo, e a superação de obstáculos é tão importante quanto a criação das próprias soluções. A consolidação dessas tecnologias depende de um ecossistema favorável que incentive a pesquisa, o investimento e a adoção em larga escala.
O país tem o potencial de não apenas resolver seus próprios problemas ambientais, mas também de exportar conhecimento e tecnologia, tornando-se um líder global em sustentabilidade. Para isso, é fundamental um olhar atento para a infraestrutura, a legislação e a educação.
Financiamento e Políticas Públicas
Um dos maiores desafios para o avanço das tecnologias sustentáveis é o financiamento. Embora haja um crescente interesse em investimentos verdes, a disponibilidade de capital de risco e linhas de crédito específicas ainda precisa ser ampliada. Em 2025, espera-se que políticas públicas mais robustas, como incentivos fiscais para empresas que investem em sustentabilidade e fundos de fomento à pesquisa e desenvolvimento, impulsionem ainda mais o setor. A clareza regulatória e a estabilidade jurídica são igualmente importantes para atrair investimentos e garantir a segurança dos projetos.
- Linhas de Crédito Verde: Acesso facilitado a empréstimos para projetos sustentáveis.
- Incentivos Fiscais: Redução de impostos para empresas que adotam práticas e tecnologias verdes.
- Marcos Regulatórios Claros: Legislação que apoie e fomente a inovação sustentável.
Educação e Conscientização
A adoção de novas tecnologias e práticas sustentáveis depende em grande parte da educação e da conscientização da população. Em 2025, mais esforços serão direcionados para programas educacionais que abordem a importância da sustentabilidade, desde as escolas até o ambiente corporativo. A conscientização sobre os benefícios das tecnologias verdes não apenas gera demanda, mas também forma uma força de trabalho qualificada para desenvolver e implementar essas soluções. A cultura de sustentabilidade é um motor para a inovação.
Além disso, a colaboração entre universidades, centros de pesquisa, empresas e o governo é fundamental para criar um ambiente de inovação vibrante. Parcerias estratégicas podem acelerar o desenvolvimento e a comercialização de novas tecnologias, garantindo que o Brasil continue na vanguarda da sustentabilidade global.
Em conclusão, os desafios para as tecnologias sustentáveis brasileiras 2025 são superáveis, e as oportunidades são imensas. Com o apoio adequado de políticas, financiamento e educação, o Brasil tem tudo para consolidar sua posição como um líder em inovação verde, contribuindo significativamente para um planeta mais saudável e um futuro mais próspero.
| Tecnologia | Descrição Breve |
|---|---|
| Energias Renováveis | Avanços em painéis solares (perovskitas/bifaciais) e sistemas de armazenamento (baterias de fluxo/hidrogênio verde). |
| Biocombustíveis Avançados | Etanol de 2ª geração de biomassa e biocombustíveis de microalgas, reduzindo dependência de fósseis. |
| Agricultura Sustentável | Agricultura de precisão com IA, biotecnologia e bioinsumos para maior produtividade e menor impacto. |
| Gestão de Resíduos e Economia Circular | Reciclagem avançada, upcycling e biodigestão de orgânicos, transformando lixo em recurso e energia. |
Perguntas Frequentes sobre Tecnologias Sustentáveis Brasileiras 2025
As principais áreas incluem energias renováveis e armazenamento, biocombustíveis avançados, agricultura sustentável e biotecnologia, gestão de resíduos e economia circular, além de cidades inteligentes e infraestrutura verde. O Brasil está investindo em soluções que visam descarbonizar diversos setores e promover um desenvolvimento mais equilibrado.
O Brasil está investindo em pesquisa e desenvolvimento de tecnologias de armazenamento além das baterias de íon-lítio, como baterias de fluxo, de estado sólido e sistemas de hidrogênio verde. A integração dessas soluções com redes inteligentes (smart grids) é crucial para garantir a estabilidade e a confiabilidade do fornecimento de energia limpa.
A biotecnologia é fundamental para desenvolver culturas mais resistentes a pragas e doenças, reduzindo a necessidade de pesticidas. Além disso, ela impulsiona a produção de bioinsumos (biofertilizantes e biopesticidas), que substituem produtos químicos sintéticos, promovendo uma agricultura mais limpa, eficiente e adaptada às mudanças climáticas.
A gestão de resíduos contribui significativamente através da reciclagem avançada, upcycling e biodigestão de orgânicos. Essas tecnologias transformam o lixo em novos recursos, como materiais e energia (biogás/biometano), reduzindo a quantidade de resíduos em aterros e diminuindo as emissões de metano, um potente gás de efeito estufa.
Os desafios incluem a necessidade de maior financiamento e políticas públicas robustas, como incentivos fiscais e linhas de crédito verde. Além disso, a educação e a conscientização da população são cruciais para a adoção em larga escala dessas tecnologias, bem como a colaboração entre os setores público e privado para impulsionar a inovação.
Conclusão
As tecnologias sustentáveis brasileiras 2025 representam um farol de esperança na luta global contra as mudanças climáticas. Desde a revolução nas energias renováveis e o avanço dos biocombustíveis, passando pela agricultura de precisão e a biotecnologia, até a transformação da gestão de resíduos e a construção de cidades inteligentes, o Brasil demonstra um compromisso notável com a inovação verde. O país, com sua vasta biodiversidade e capacidade criativa, está pavimentando um caminho para um futuro mais sustentável, não apenas para si, mas para o mundo. Contudo, para que essas inovações atinjam seu pleno potencial, é imperativo o contínuo investimento em pesquisa, o desenvolvimento de políticas públicas favoráveis e uma crescente conscientização da sociedade. A jornada é desafiadora, mas as oportunidades são imensas, e o Brasil está pronto para liderar essa transição vital para um planeta mais saudável e resiliente.





